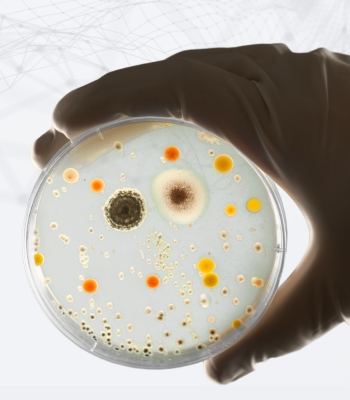

Un pilar fundamental en la cadena de suministro para la investigación científica y la mejora de la calidad de vida de la sociedad.

Desde 1993, D Q Microbiología ha sido un eslabón clave en la cadena de suministro de material para laboratorio en México, abasteciendo con precisión a hospitales y centros de investigación en sectores como el clínico, farmacéutico, veterinario, alimentario y académico.
Sabemos que cada diagnóstico y análisis depende de insumos y equipos de calidad, por eso trabajamos con marcas líderes en el sector como Becton Dickinson, Corning o Zeulab (entre muchas otras) y con una estructura operativa que garantiza cobertura nacional, entregas oportunas y soporte técnico especializado.
Nuestro objetivo es claro: facilitar que quienes investigan puedan concentrarse en lo esencial —descubrir, innovar y mejorar la calidad de vida— mientras nosotros nos ocupamos de que nunca les falte lo necesario para lograrlo.

Equipo, experiencia y próposito al servicio del cliente
Nuestros productos y servicios están orientados a resolver con precisión las necesidades de cada cliente.
Creemos firmemente que nuestro equipo humano es el motor que impulsa la calidad y el crecimiento de la empresa. Por eso, trabajamos para que su bienestar y el de sus familias esté siempre ligado al desarrollo de nuestra organización.
Como empresa, nos comprometemos a construir un negocio sostenible, rentable y con impacto positivo, que haga realidad el propósito que nos une
Lo lograremos apostando por la mejora continua, el conocimiento, la innovación comercial y el fortalecimiento de nuestro equipo.
En un entorno cambiante, enfocamos nuestra visión en resultados medibles y sostenibles, con la meta de posicionarnos como una de las principales opciones del mercado nacional en los próximos años.
-
Orientación al cliente
El servicio personalizado es el núcleo de nuestra cultura. -
Armonía y respeto
Fomentamos un ambiente colaborativo, humano y profesional. -
Integridad y honestidad
Actuamos con ética, haciendo siempre lo correcto. -
Compromiso del equipo
Nuestro personal es el motor que impulsa cada logro y nos permite avanzar junto a nuestros clientes.














